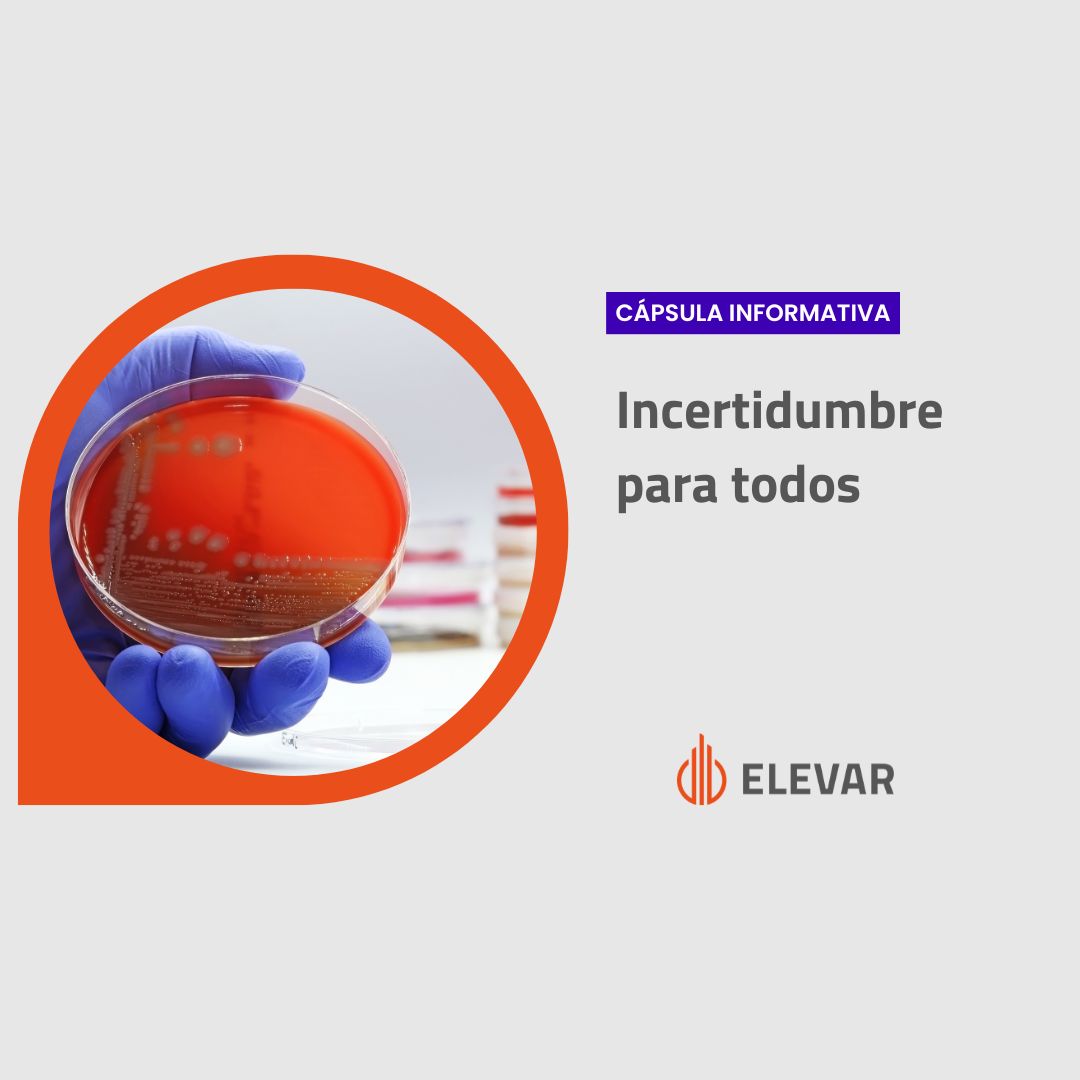
3 componentes de la incertidumbre en microbiología según ISO 19036

Get Support
123-456-789-10
Blog
Cápsula informativa
Cápsula informativa
3 componentes de la incertidumbre en microbiología según ISO 19036
¿Conoces los 3 componentes de la incertidumbre en microbiología?Para conoc...
[ Leer más ].jpg) Cápsula informativa
Cápsula informativa
Fuentes de detección de no Conformidades
¿En qué momento se detectan no conformidades en tu laboratorio?Es interesa...
[ Leer más ].jpg) Cápsula informativa
Cápsula informativa
Relación entre veracidad, precisión y exactitud
Te compartimos este blog para aclarar dudas y definir conceptos, tomando c...
[ Leer más ].jpg) Cápsula informativa
Cápsula informativa
Auditorias internas y cultura de calidad
Muchas veces nos sucede como auditores internos que es complicado encontra...
[ Leer más ].jpg) Cápsula informativa
Cápsula informativa
Información documentada que mantener y conservar
¿Sabés la diferencia entre la información documentada que se debe mantener...
[ Leer más ].jpg) Cápsula informativa
Cápsula informativa
Priorización de tareas en el laboratorio
Llegás al laboratorio y te espera un día con una rutina agitada y la mente...
[ Leer más ].jpg) Cápsula informativa
Cápsula informativa
Rotulado de reactivos en el laboratorio de química
En el laboratorio preparamos una gran cantidad de reactivos... soluciones...
[ Leer más ].jpg) Cápsula informativa
Cápsula informativa
Numeral 7.7.1.h "Correlación de resultados para diferentes características de un ítem" - Norma ISO/IEC 17025
Cuando debemos interpretar la norma ISO/IEC 17025 para su aplicación, en o...
[ Leer más ].jpg) Cápsula informativa
Cápsula informativa
No conformidad en más de un requisito
Hace un tiempo me preguntaron si una misma No Conformidad puede aplicar a...
[ Leer más ]